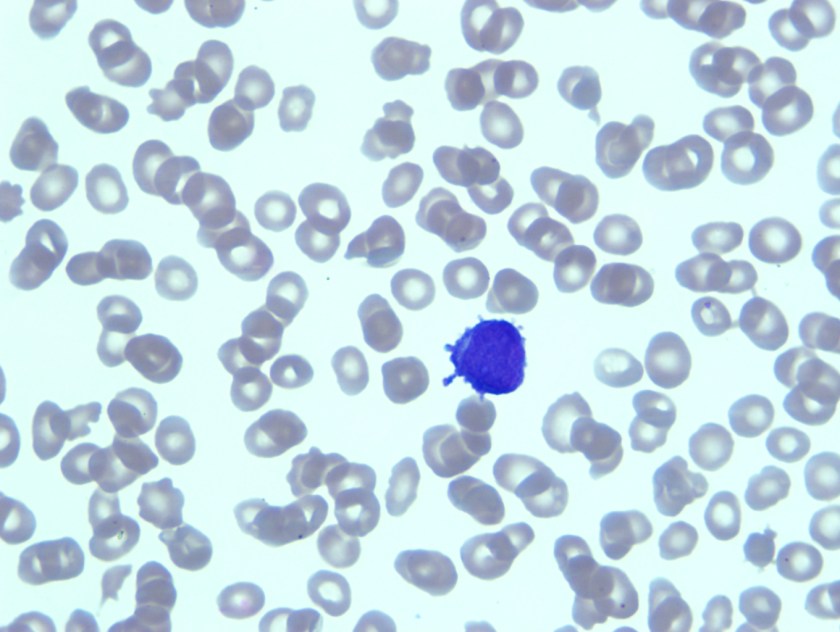
aml1
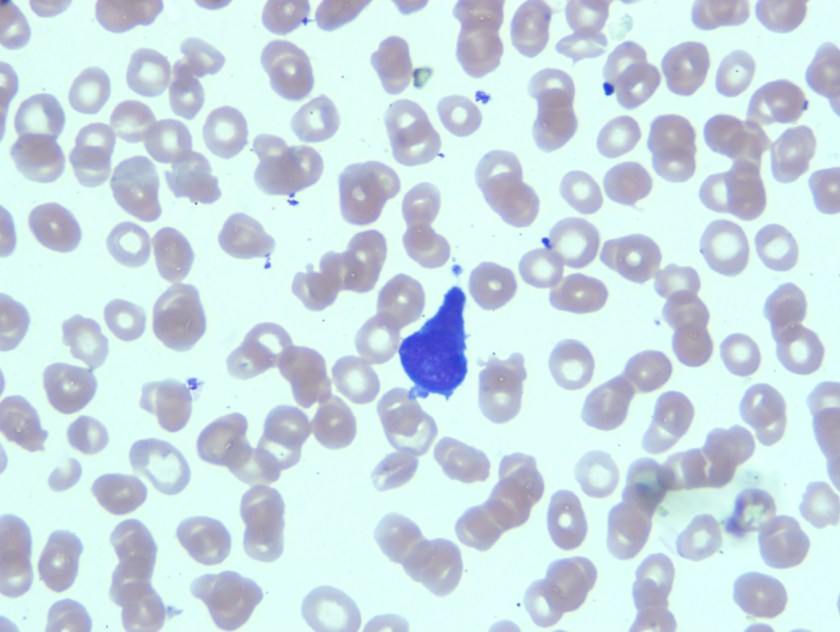
aml2
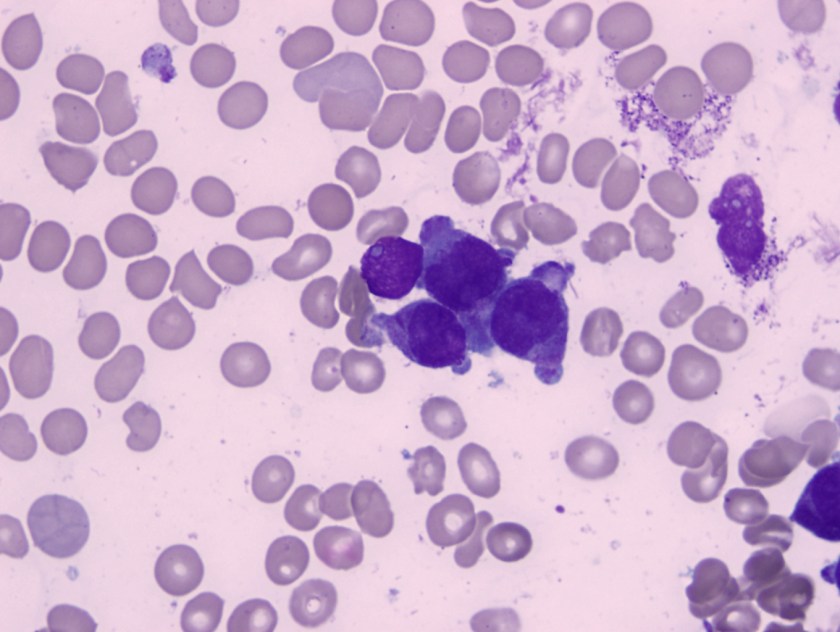
aml3
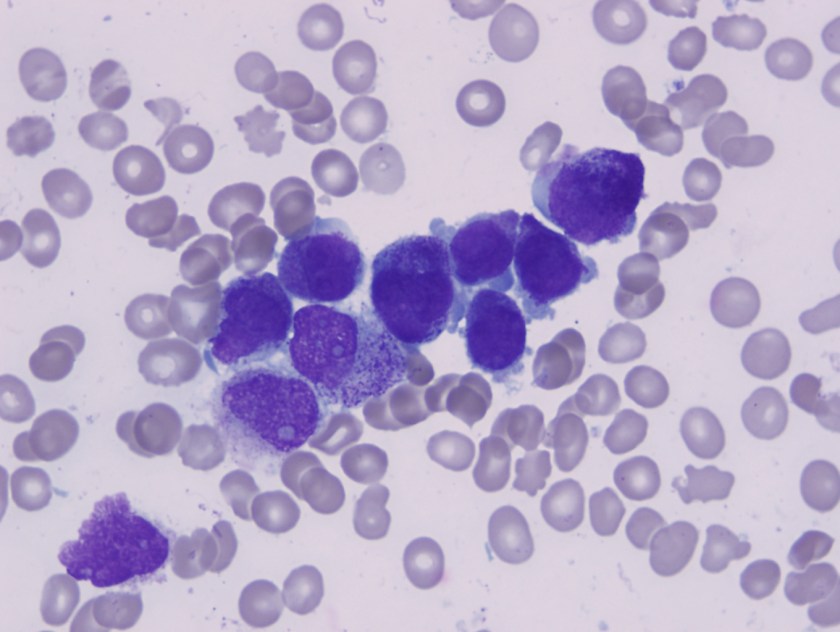
aml4

It’s been a while since my last blog. I haven’t had as much time and energy as I would like this past year. For now, I’ll just say…appreciate all that your chief residents do because much more time and effort lies beneath the surface than everyone is able to see.
But the topic for this blog is the value of electives during pathology residency. Our programs vary with respect to electives in terms of number and ability to take them externally or not. My previous program had five electives that could be taken internally or externally. However, external electives did not receive salary support and I didn’t take any electives although I could’ve during my two years in Chicago. Since we had a decent number of electives, many residents scheduled them internally during fourth year to have lighter months to study for boards although a handful did utilize them during earlier years for external electives.
My current program has two and we do receive salary support with external electives. For my first, I had an extra month of hematopathology internally because I wanted to see another perspective on one of my chosen subspecialties. Internal electives are good to spend more focused time in an area of subspecialty interest that you may have for fellowship. It also allows for the opportunity to develop deeper relationships with the faculty who will most likely be writing your letters of recommendation for that fellowship. They may also provide you with the opportunity to become more involved in research and/or publications (eg – book chapters, case reports, research articles) with a mentor and these are all helpful in enhancing your fellowship and future job applications and build up your CV.
Currently, I’m on an external elective at the institution where I’ll do both my hematopathology and molecular genetic fellowships. I’m laying the groundwork for molecular hematopathology research now that hopefully results in data analysis over the ensuing months to culminate in an abstract submission for the American Society of Hematology (ASH) which has a deadline only a month after I start fellowship. I also want to use this time away to get to know people at my future program better, prepare for my eventual move here, and study for boards. Hopefully, I’ll also get a sense of the daily work flow as I am also attending signouts and intra- and interdepartmental conferences so that I can manage my time as efficiently as I can from day 1 of fellowship. I really like the culture and people here, but that’s subject matter for a future blog. I also am enjoying the benefits of attending inter-program activities as TMC is the largest medical center in the world with active interaction and collaboration between member hospitals. Not so much in my case since I obtained both my consecutive fellowships last year as a PGY-3, but for many, the value of an early external elective is that it can be seen it as an “audition” rotation to obtain a desired fellowship. You may even be able to ask for an interview before you finish (which saves you time and money). I also have some friends who were offered fellowship spots at the end of their elective rotation because they impressed the fellowship director. Obtaining fellowship positions is pretty competitive and there tends to be fewer spots than there are for residency. And in many cases, positions are not even available if an internal candidate is chosen early (even during their PGY-1) so anything to augment your fellowship application is a plus.
Now that I’ve mentioned external electives, I’d like to give some advice on setting up an external elective. First, start as EARLY as possible! Even a year or more before isn’t too early to ask about getting the ball rolling. Start preparing and updating your CV from your PGY-1 as you’ll need this for both external elective and fellowship applications. Scan and keep a PDF of all your vaccinations and work-related health requirements (eg – PPD/Quantiferon results, flu vaccine, hepatitis B testing, MMR and hepatitis B antibody titers, and N-95 fit testing) as well because its likely you’ll also have to include this in your external elective application.
I initiated the elective rotation request about a half year prior to the actual rotation. And even then, that was not early enough and everything came down to the wire. It’s far more complicated than when we applied for elective rotations as a medical student and takes much more time. Since we are now physicians, you are more than likely required to have at least a medical permit in that state to rotate and this process can take a while. Also the back-and-forth between program coordinators and the respective GME departments can appear glacial at times, and in my case, was the main cause of delay. I hit several delays at obtaining paperwork (especially between Christmas and New Year’s when many staff were off at both programs, my medical school, and the Texas Medical Board where I needed paperwork from). It can be time-consuming to have to make multiple phone calls, and often, the process cannot be completed until its antecedent step has been approved. I know residents who have had to postpone external rotations because paperwork between GME departments (eg – PLAs or malpractice agreements) were not in place in time. Maintaining constant and open communication between all parties involved is a must and sometimes easier said than done the more people that are involved.
In addition to obtaining the state medical permit (which generally requires an application fee; in my case, $135), there may be other requirements that are also time-consuming and financially expensive. You may be required to do pre-employment-type health screening (in my case, a $36 urine drug screen) at your own cost as you are not a true employee. I also had to become ACLS certified (at $120, despite being BLS certified and a former American Red Cross CPR instructor). But since I’m going to be a fellow here, I can get it reimbursed through my GME funds and would have to do it later anyways so I might as well do it now. But if you are not doing an elective at your future fellowship institution, it’s good to find out what items may incur cost in your application for your elective since you are not likely to get reimbursed and so you can decide whether those expenses are acceptable. One way to defray costs is to apply for grants such as the ASCP subspecialty grant which is administered to six residents twice a year (Jan/Aug). In fact, the next deadline is this Friday, Jan 15th! You can find more information on how to apply at http://www.ascp.org/Residents/Resident-Grants.

-Betty Chung, DO, MPH, MA is a fourth year resident physician at Rutgers – Robert Wood Johnson University Hospital in New Brunswick, NJ.